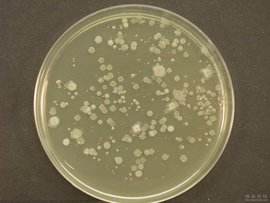
懸浮培養基(SM,2%)

甲基纖維素溶液(2%,粘度4000cps)由上海遠慕生化試劑廠家提供,本司是家老牌生化試劑供應商,長期現貨供應不同類的細胞裂解液,標準品,對照品,動物血清,化學試劑,培養基,抗體,抗原,多肽,酶類,生物分子,微生物,染色液,溶液,緩沖液,實驗耗材及其他試劑的,細胞裂解液部分展示:ACK紅細胞裂解液(ACK Lysis Buffer),Gey's紅細胞裂解液(Gey's Lysis Buffer),紅細胞裂解液(RBC Lysis Buffer,10×),Triton-NH4OH細胞裂解液,歡迎選購!
產品名稱:甲基纖維素溶液(2%,粘度4000cps)
規格:50ml
供應商:上海遠慕生物
分類:細胞培養
儲存條件:4℃,12個月
用途:用于美希索中細胞的克隆培養,2%粘度為4000cps以上。懸浮培養基組成成分,細胞集落培養,分離細胞集落
注意事項:水溶液,經高壓滅菌處理。甲基纖維素Methyl cellulose,也稱作美希索。
【注意事項】
1、制備細胞懸液是應根據具體實驗需要,不一定要制備成單細胞懸液。
2、后續試驗如果是用于細胞培養,操作過程中應注意無菌操作,盡量在超凈工作臺內操作。
3、離心步驟盡量在4℃離心機上操作。
4、常規步驟與快速步驟的區別在于:常規步驟多了一步洗滌過程的離心,可以節省洗滌液的用量,并且洗滌效果也更好,不需要大體積的離心管;快速步驟少了一次離心過程,洗滌效果略差一些,同時需要大體積的離心管。
5、離心洗滌后,通常極微量的紅細胞不會影響后續的檢測。
6、如果經過Tris-NH4ClLysisBuffer處理后的樣品后續用于總RNA的提取,在處理細胞時不必使用DEPC處理的溶液,即無需在該操作中特意去除RNase。
7、為了您的安全和健康,請穿實驗服并戴一次性手套操作。
產品名稱:甲基纖維素溶液(2%,粘度4000cps)
規格:50ml
供應商:上海遠慕生物
分類:細胞培養
儲存條件:4℃,12個月
用途:用于美希索中細胞的克隆培養,2%粘度為4000cps以上。懸浮培養基組成成分,細胞集落培養,分離細胞集落
注意事項:水溶液,經高壓滅菌處理。甲基纖維素Methyl cellulose,也稱作美希索。
【注意事項】
1、制備細胞懸液是應根據具體實驗需要,不一定要制備成單細胞懸液。
2、后續試驗如果是用于細胞培養,操作過程中應注意無菌操作,盡量在超凈工作臺內操作。
3、離心步驟盡量在4℃離心機上操作。
4、常規步驟與快速步驟的區別在于:常規步驟多了一步洗滌過程的離心,可以節省洗滌液的用量,并且洗滌效果也更好,不需要大體積的離心管;快速步驟少了一次離心過程,洗滌效果略差一些,同時需要大體積的離心管。
5、離心洗滌后,通常極微量的紅細胞不會影響后續的檢測。
6、如果經過Tris-NH4ClLysisBuffer處理后的樣品后續用于總RNA的提取,在處理細胞時不必使用DEPC處理的溶液,即無需在該操作中特意去除RNase。
7、為了您的安全和健康,請穿實驗服并戴一次性手套操作。
售前服務:
產品介紹,技術疑難解答
售中服務:
守信合同,保證及時供貨,隨時保持與客戶聯系
售后服務:
1.對用戶所有疑問,快速做出反映,售后服務人員在2~3個工作日內給您一個滿意的答復。
2.產品如有質量問題,遠慕實行包退、包換服務。
專業生產、專業服務,遠慕為你創造更多價值
不斷提升服務質量,精益求精,“真誠的服務”是遠慕永恒的主題
產品介紹,技術疑難解答
售中服務:
守信合同,保證及時供貨,隨時保持與客戶聯系
售后服務:
1.對用戶所有疑問,快速做出反映,售后服務人員在2~3個工作日內給您一個滿意的答復。
2.產品如有質量問題,遠慕實行包退、包換服務。
專業生產、專業服務,遠慕為你創造更多價值
不斷提升服務質量,精益求精,“真誠的服務”是遠慕永恒的主題
遠慕生物訂購流程如下:
1、絕大部分產品備有現貨,一般情況下都能訂貨當日發貨。
2、部分非常用產品,需提前1-2日預訂,海外期貨則需要提前3-6周預訂。
3、部分產品價格會因貨期、批次等因素發生變化,若有變動以訂貨當日價格為準。
4、每日訂單截止時間為18點整,部分城市可到19點整,因超過截止時間造成當日不能發貨的將于次日安排發貨。
5、請辦理完貨款后,將收據、底單等連同收貨人的地址、姓名、電話等以傳真、EMail、電話等形式通知我們。


TOP_QPJS_Q0N.png)


TOP_QPJS_Q0N.png)

TOP_QPJS_Q0N.png)